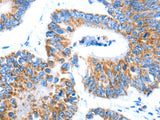
AIFM1 Polyclonal Antibody Store at -20°C

AIFM1 Polyclonal Antibody Store at -20°C
SKU: E-AB-10123-200
AIFM1 Polyclonal Antibody Store at -20°C
| SKU # | E-AB-10123 |
| Reactivity | Human, Mouse, Rat |
| Host | Rabbit |
| Applications | WB, IHC |
Product Details
| Isotype | IgG |
| Host | Rabbit |
| Reactivity | Human, Mouse, Rat |
| Applications | WB, IHC |
| Clonality | Polyclonal |
| Immunogen | Recombinant protein of human AIFM1 |
| Abbre | AIFM1 |
| Synonyms | 1, AIFM1, Apoptosis inducing factor, Apoptosis inducing factor 1, Apoptosis-inducing factor 1, CMTX4, COWCK, COXPD6, Harlequin, Hq, MGC111425, MGC5706, Neuropathy, axonal motor-s, mAIF, mitochondrial, mitochondrion associated |
| Swissprot | |
| Calculated MW | 67 kDa |
| Cellular Localization | Mitochondrion intermembrane space. Mitochondrion inner membrane. Cytoplasm. Nucleus. Cytoplasm>perinuclear region. Proteolytic cleavage during or just after translocation into the mitochondrial intermembrane space (IMS) results in the formation of an inner-membrane-anchored mature form (AIFmit). During apoptosis, further proteolytic processing leads to a mature form, which is confined to the mitochondrial IMS in a soluble form (AIFsol). AIFsol is released to the cytoplasm in response to specific death signals, and translocated to the nucleus, where it induces nuclear apoptosis. Colocalizes with EIF3G in the nucleus and perinuclear region. |
| Concentration | 0.2 mg/mL |
| Buffer | Phosphate buffered solution, pH 7.4, containing 0.05% stabilizer and 50% glycerol. |
| Purification Method | Affinity purification |
| Research Areas | Cancer, Cell Biology, Epigenetics and Nuclear Signaling, Metabolism |
| Conjugation | Unconjugated |
| Storage | Store at -20°C Valid for 12 months. Avoid freeze / thaw cycles. |
| Shipping | The product is shipped with ice pack,upon receipt,store it immediately at the temperature recommended. |
Related Reagents
| Applications | Recommended Dilution |
| WB | 1:500-1:2000 |
| IHC | 1:25-1:100 |
Background
This gene encodes a flavoprotein essential for nuclear disassembly in apoptotic cells, and it is found in the mitochondrial intermembrane space in healthy cells.Induction of apoptosis results in the translocation of this protein to the nucleus where it affects chromosome condensation and fragmentation.In addition, this gene product induces mitochondria to release the apoptogenic proteins cytochrome c and caspase-9.Mutations in this gene cause combined oxidative phosphorylation deficiency 6, which results in a severe mitochondrial encephalomyopathy.Alternative splicing results in multiple transcript variants.A related pseudogene has been identified on chromosome 10.